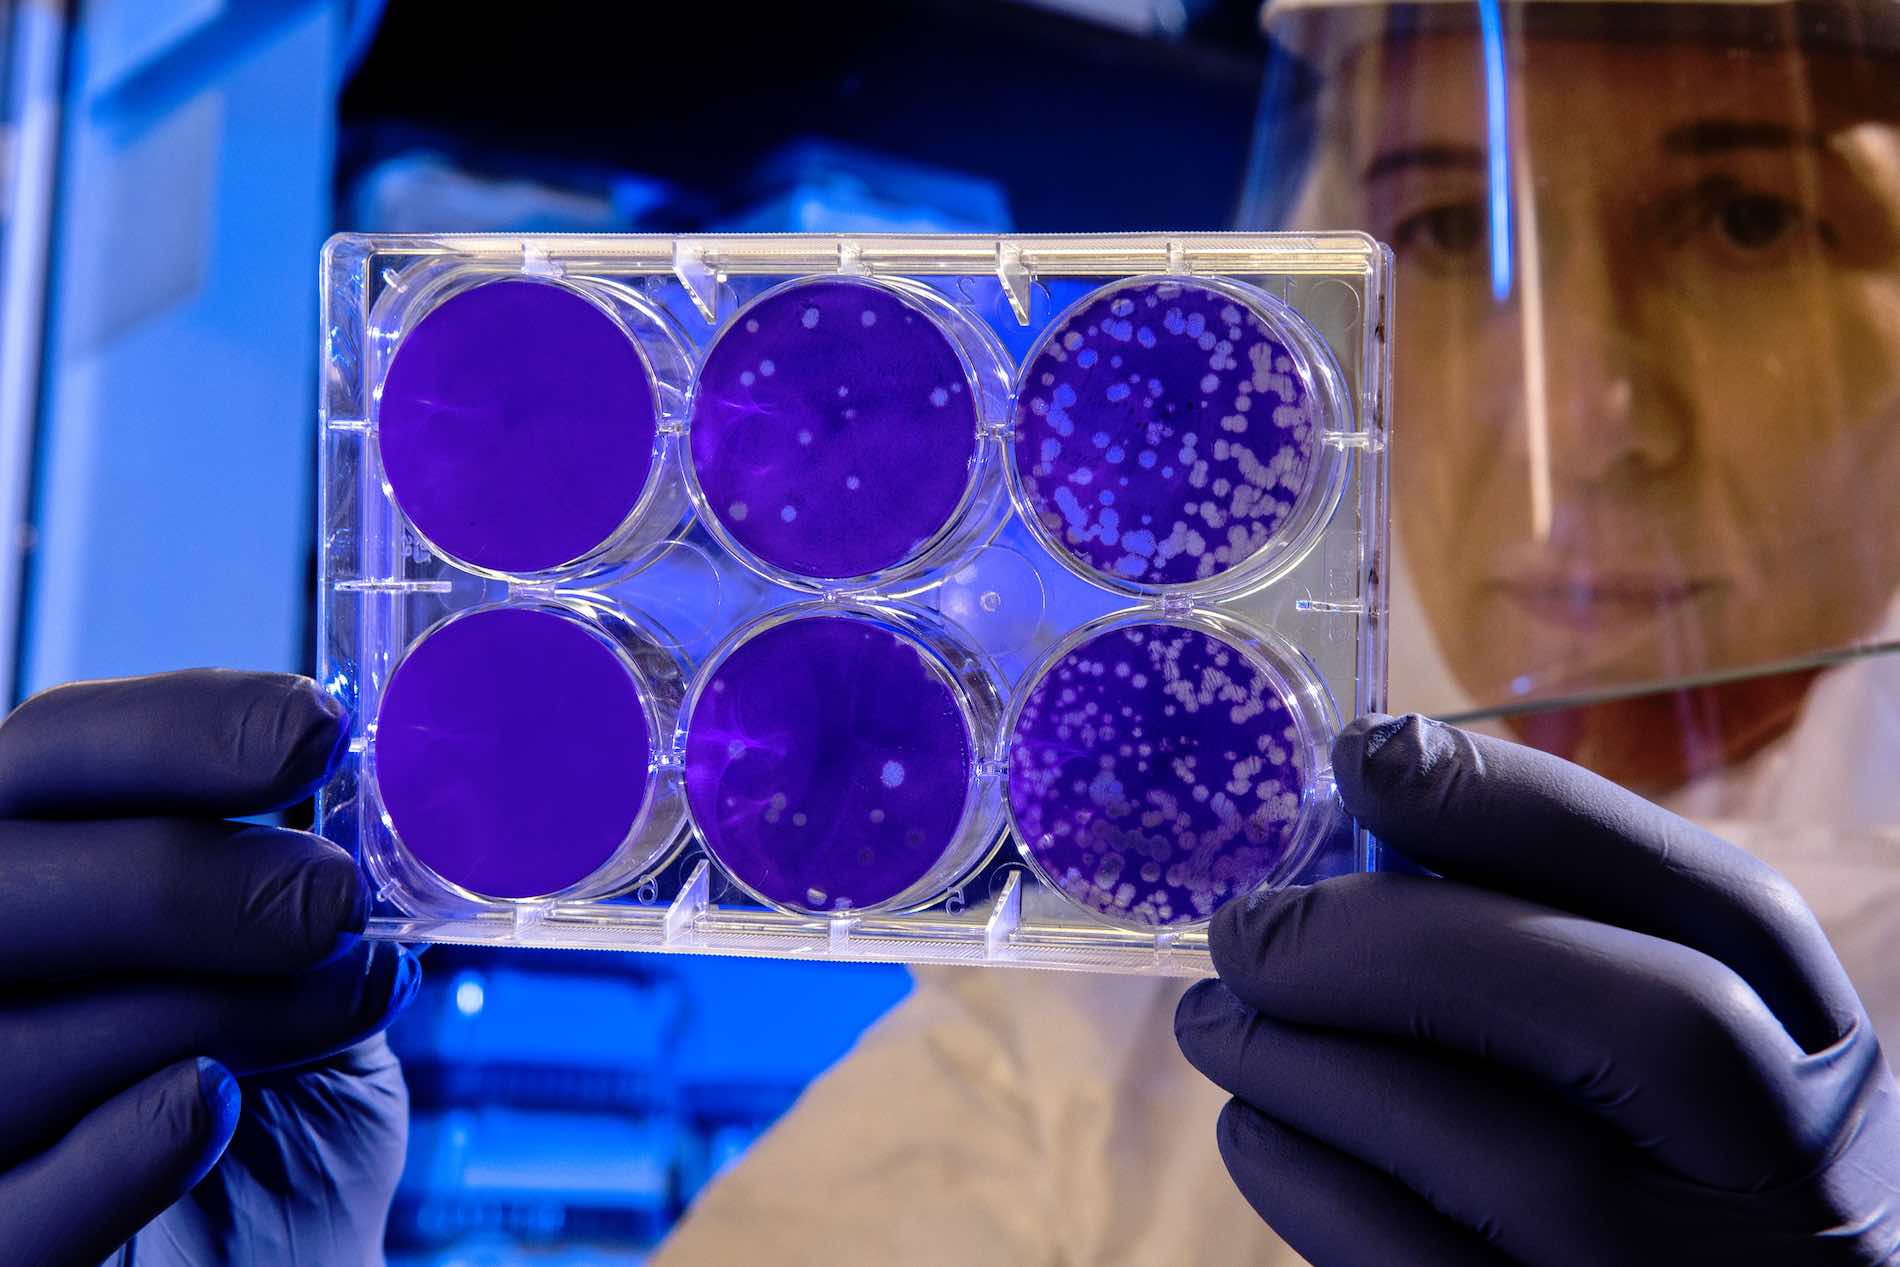
estrategia digital frente al coronavirus

El coronavirus amenaza con alterar drásticamente la forma en que las personas y las empresas experimentamos las cosas en 2020.
En La Gran Manzana queremos insistir en que ahora más que nunca, la empresas deben asumir estrategias de marketing digital como medida indispensable de supervivencia.
Nos sumamos a las recomendaciones de las autoridades que exigen a los ciudadanos quedarse en casa y aconsejan el uso de canales digitales para seguir desarrollando la actividad comercial y de crecimiento.
En La Gran Manzana analizamos este tema tan actual y ofrecemos algunas ideas sobre cómo las marcas pueden crear nuevos planes en sus estrategias de marketing online, o alterar aquellos que ya tienen en marcha.
Resumen de 30 segundos:
- A medida que los eventos en todo el mundo se cancelan o posponen, las marcas deben pensar en cómo poner online todos los elementos importantes del marketing.
- Los profesionales del marketing pueden descubrir que tienen un nuevo elemento en la descripción de su trabajo: crear experiencias exclusivamente online que hacen que las personas se sientan tan conectadas como en las experiencias en persona.
- El correo electrónico puede ser una excelente manera de crear una línea de comunicación más directa con las personas en torno a un evento o experiencia.
- De cualquier manera, el valor real es dar vida a las experiencias digitales para un compromiso más profundo con las personas.
Por qué el coronavirus afecta la estrategia digital de tu negocio
La mayoría de las personas caen en uno de estos 2 estados cuando se trata de la pandemia actual de Coronavirus.
¡El papel higiénico dispara el modo de pánico de las personas o los medios de comunicación nos están exagerando y tampoco hay para tanto!
De acuerdo, son dos extremos del espectro, pero no se puede escapar al hecho de que, independientemente de cuál sea la verdad, está impactando nuestra forma de vida de manera dramática.
Las escuelas han cerrando, los eventos de cualquier tipo se han cancelado, las ligas deportivas profesionales están suspendidas y, lamentablemente, incluso muchas empresas están al borde de tener que cerrar sus puertas permanentemente.
Entonces, no importa cuál sea tu opinión sobre lo conseguido por este virus y su amenaza para la sociedad, no se puede negar que está creando un efecto multiplicador sobre lo que ya era una tendencia hacia el comportamiento de compra online frente a la tradicional compra offline.
No había duda de que nuestras nuevas generaciones ya vivían estilos de vida predominantemente digitales … .
Si tienes un negocio, ahora es el momento de pensar mucho sobre cómo tu empresa está invirtiendo en estrategias digitales y si estás preparado para atender el cambio que se ha producido en el nuevo escenario en el que nos encontramos.


No importa si tus productos o servicios están diseñados para experiencias en la tienda física, ahora es el momento de repensar cómo tu negocio puede evolucionar para garantizar que sobreviva a esta dinámica cambiante.
Ya sea creando nuevas líneas de productos, aprovechando mejor el marketing de contenidos y las estrategias de redes sociales para mantener a los clientes conectados a tu marca, o incluso pensando más en las nuevas ideas de negocios que capitalizan exclusivamente en un mundo digital, debes pensar de manera diferente.
Los servicios de entrega basados en suscripción, las ofertas o promociones y todo aquello que fomente servicios a medida para que más y más personas elijan comprar y tomar sus decisiones de compra desde la comodidad y seguridad de sus propios hogares.
Una reciente investigación de Nielsen identificó seis niveles clave de umbral de comportamiento del consumidor que se relacionan directamente con las preocupaciones sobre el nuevo brote de coronavirus (COVID-19).
Los umbrales ofrecen señales tempranas de patrones de gasto, particularmente para artículos de despensa de emergencia y suministros de salud, y estamos viendo estos patrones reflejados en múltiples mercados.

Observa el gráfico anterior y cómo Nielsen está proyectando el impacto de esta última pandemia. Toma nota de # 4, # 5 y # 6. Las tendencias ya apuntaban en esta dirección, pero este último episodio solo aumentará la velocidad del comercio electrónico y el comportamiento de compra online.
Según el informe de Nielsen:
«Ya estamos viendo mercados adicionales que entran en el umbral de la» vida restringida «.
«A medida que los patrones comienzan a surgir en respuesta a eventos de noticias de esta naturaleza, será imperativo que las empresas aprendan de estos escenarios para que puedan mantener el crecimiento incluso en momentos en que COVID-19 ha desarraigado la vida de las personas.
Estos patrones ayudarán a proporcionar indicadores principales y finales a aquellos que intentan comprender cómo responderán las personas a medida que los desarrollos continúan desarrollándose en diferentes momentos en diferentes países ”.
Scott McKenzie, Lider en Inteligencia Global de Nielsen
El término clave de esta cita es «vida restringida».
No importa si crees en la gravedad de este virus en particular.
Lo que deberíamos considerar es la reacción y los comportamientos del mundo a partir de él, y el hecho es que la gente va a cambiar sus comportamientos de compra más que nunca.
A medida que los patrones comienzan a surgir en respuesta a eventos de noticias de esta naturaleza, será imperativo que las empresas aprendan de estos escenarios para que puedan mantener el crecimiento incluso en momentos en que COVID-19 ha desarraigado la vida de las personas.
En La Gran Manzana estamos para ayudar a conseguir clientes cualificados, encontrar ese nicho de mercado, focalizar los esfuerzos de marketing y optimizar los recursos.
Te proponemos nuestro Método para conseguir y fidelizar clientes. Empezando por definir quién es o puede ser tu Cliente Ideal.